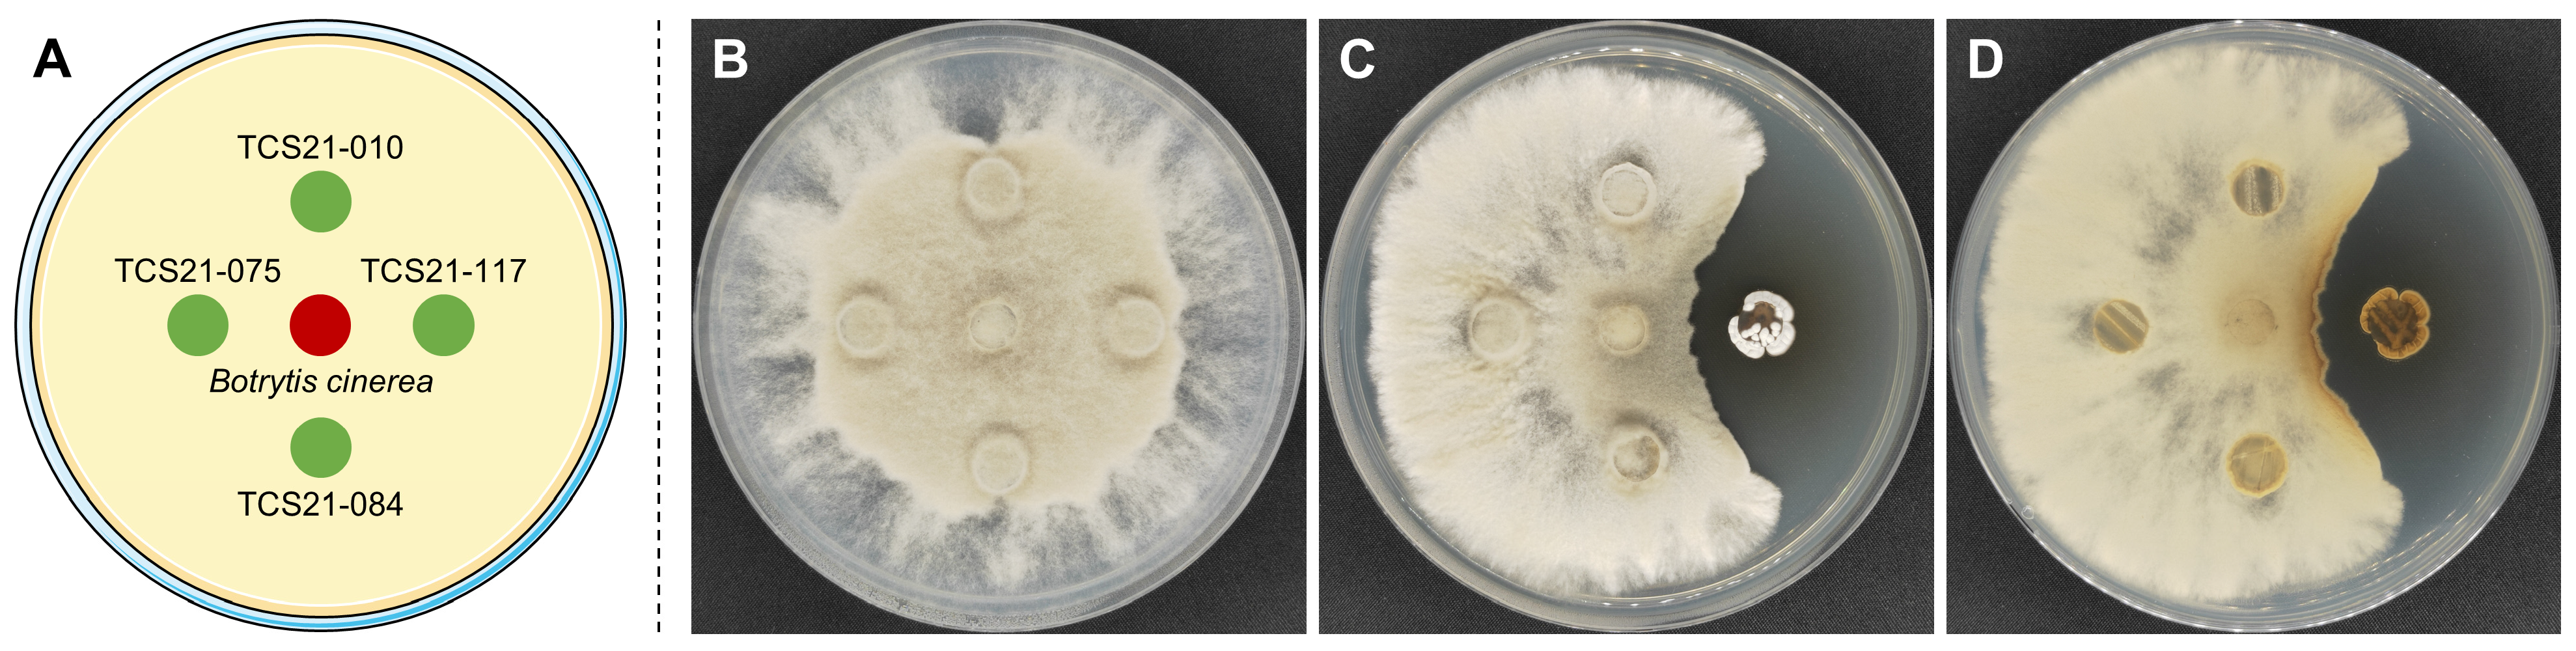
Microorganisms 13 00379 g002

1. Introduction
The genus
Streptomyces was first proposed by Waksman and Henrici in 1943 [
1] and is recognized to be one of the largest taxa among bacteria, serving as a rich source of secondary metabolites with diverse chemical structures and biological activities, particularly antibiotics [
2]. It is estimated that over 74% of commercial antibiotics are produced from the genus
Streptomyces [
3]. As of writing, 738 species of
Streptomyces have been validly published and accurately named (
www.bacterio.net/streptomyces.html, (accessed on 2 February 2025)). Members of the genus
Streptomyces represent a vast group of aerobic, Gram-positive bacteria characterized high DNA guanine and cytosine (G + C) content (69–78%) and a filamentous morphology akin to fungi [
4,
5]. A key morphological feature of this genus is the formation of long vegetative and aerial mycelia that differentiate into chains of single-celled spores [
6]. Some strains are capable of producing a wide variety of pigments. They are widely distributed across various environments, including soil, animals, plants, oceans, salt lakes, and volcanoes, with a higher prevalence in soil compared to other habitats [
7].
Botrytis cinerea, commonly known as gray mold, was ranked number 2 in a survey of the international community’s top 10 fungal plant pathogens [
8]. Presently, 38 species of
Botrytis have been formally recognized [
9]. A distinguishing feature of
B. cinerea compared to other plant pathogens is its exceptionally broad host range, capable of infecting over 1400 species of cultivated plants, particularly dicotyledonous species. Infestation can occur from the seedling stage to product ripening, presenting significant challenges to agricultural production. Annual economic losses due to
B. cinerea are estimated to exceed USD 10 billion globally [
10]. Moreover, most species and isolates of
Botrytis exhibit a complex life cycle and flexible infection modes [
11]. Infection can occur not only through the production of spores and mycelium but also via the formation of sclerotia during overwintering [
12].
Chemical control is the most widely used and effective method for preventing and managing
Botrytis cinerea, but one of its major drawbacks is the development of more aggressive resistant strains [
13]. Additionally, chemical pesticides can be toxic to various organisms, including birds, fish, beneficial insects, and non-target plants, as well as impacting air, water, soil, and crops [
14]. For instance, in the US, atrazine has been detected in approximately 75% of stream water samples, posing risks to aquatic ecosystems and drinking water quality [
15]. Furthermore, there are approximately 385 million instances of unintentional acute pesticide poisoning each year, resulting in approximately 11,000 fatalities [
16]. Therefore, the development of methods that complement chemical control, such as the use of non-pathogenic microorganisms as biological control agents (BCAs), is increasingly viewed as a promising alternative [
17].
Building on the challenges posed by chemical control methods for managing Botrytis cinerea, this study evaluated 132 strains of actinomycetes for their antifungal activities against the pathogen. Among them, the strain TCS21-117 demonstrated notable antagonistic activity against B. cinerea. For further study, a series of assays, including broad-spectrum antifungal activity, polyphasic taxonomy, and fermentation optimization assays, were performed, which can enrich the beneficial microbial resource bank for biocontrol, and are expected to present an effective biological agent to control plant diseases.
4. Discussion
The discovery of novel bioactive compounds is an ongoing process [
46]. One of the more effective methods for discovering novel metabolites from microorganisms is through the isolation of new microbial species [
47]. Soil, as the natural culture medium, contains a diverse array of microorganisms that produce biologically active compounds. However, less than 1% of the microbial community can be cultivated by using conventional culturing techniques, leaving the remaining 99% of microorganisms unexplored [
48]. New species of
Streptomyces may possess unique characteristics and produce specific secondary metabolites.
In this study, a total of 132 strains of actinomycetes were isolated from 60 soil samples using five kinds of media. However, the 16S rRNA gene sequencing showed that these isolates were mostly
Streptomyces. This indicates that the isolation method has some limitations and requires further improvement. The literature showed that the main factors affecting the separation of actinomycetes include the different pretreatment methods and media combinations [
49]. Kang et al. [
50] reported that the separation effect of actinomycetes was effective when the soil samples were treated for 7 to 10 days by air drying, resulting in a greater number and more types of actinomycetes, while it significantly reduced the presence of miscellaneous bacteria. According to the study by Si et al. [
51], pretreatment of air-dried soil samples with dry heat at 100 °C for 60 min facilitated the germination of actinomycete spores and increased both the number and species of actinomycetes. However, the effectiveness of heat treatment on reducing bacterial growth was not optimal. Yang et al. [
52] examined the effects of different actinomycetes on inhibitors of potassium bichromate and found that potassium bichromate was a highly selective, effective, and inexpensive inhibitor that could suppress most soil fungi and bacteria but not actinomycetes. In addition, many studies have shown that ISP series media (ISP-2, ISP-4, ISP-5) exhibit high selectivity for the actinomycete group.
The plate confrontation method and the mycelial growth rate method performed in this study have been widely applied in the screening of beneficial microorganisms with biocontrol potential. In this study, strain TCS21-117 showed moderate antagonistic activity to
R. solani on the PDA plate; however, the fermentation broth of strain TCS21-117 showed almost complete inhibition against
R. solani. This phenomenon can be attributed to at least two factors. One reason is that the change in the culture method (solid-state and liquid) has altered the expression patterns of the secondary metabolic pathways within strain TCS21-117 [
53]. Another is the difference in growth rates between fungi and actinomycetes; the growth and reproduction of actinomycetes are slower than those of fungi [
21]. Consequently, it takes longer for actinomycetes to colonize and produce active substances on the plate, and the diffusion of these active substances also requires time, which may not be sufficient to inhibit pathogenic fungal growth.
Strain TCS21-117 was identified as
Streptomyces using traditional classification methods and 16S rRNA gene sequencing technology. It was found that strain TCS21-117 was most closely related to
Streptomyces roietensis WES2
T (98.58% 16S rRNA gene sequence similarity) and
Streptomyces colonosanans MUSC 93J
T (98.07%) (
Table 5). These closely related
Streptomyces strains are known to produce a range of useful antibiotics. However, there are notable differences between strain TCS21-117 and its closely related strains regarding phenotypic, physiological, and biochemical properties. Strain TCS21-117 can be easily distinguished from its most closely related species by cultural characteristics, such as colony colors and diffusible pigment production. Morphological characteristics, including spore chain formation and surface ornamentation, also distinguish the isolate from its closely related strains. In addition, strain TCS21-117 can grow moderately in the presence of 7% NaCl, pH 4.0 or 12.0, and 50 °C, in contrast to its closely related strains, which cannot grow under these conditions. While strain TCS-21-117 cannot utilize D-mannitol and sucrose,
S. roietensis WES2
T can [
54], allowing for differentiation between the two. Furthermore, strain TCS21-117 can utilize L-rhamnose, D-lactose, D-maltose, and D-fructose, whereas
S. colonosanans MUSC 93J
T cannot [
55], providing another distinguishing factor. Strain TCS21-117 can hydrolyze cellulose, while
S. colonosanans MUSC 93J
T cannot. Therefore, further identification is needed, including chemotaxonomic analyses and genomic studies.
Actinomycete fermentation is a complex and dynamic biological process [
56]. Studies have shown that the types and yield of fermentation products are influenced not only by the performance of the strain but also by nutrients and environmental factors, such as inoculation volume, medium capacity, fermentation time, temperature, agitation rate, and initial pH [
57]. In this study, the effects of different types of culture media and fermentation conditions on the antifungal activity of fermentation broth of strain TCS21-117 were analyzed using single-factor experiments and orthogonal tests. The results showed that PDB broth medium is highly suitable for cultivating strain TCS21-117, as it is simple, low-cost, and easy to promote. The ideal fermentation conditions were determined to be fermentation temperature of 28 °C, a duration of 7 days, an inoculation volume of 1%, a medium capacity of 125 mL, an agitation rate of 180 r·min
−1, and an initial pH of 8.0. Fermentation temperature and time significantly impact the antifungal activity of strain TCS21-117. Compared with other antagonistic
Streptomyces, other fermentation conditions such as inoculation volume had no effect on the antifungal activity of fermentation broth. This suggests that there are certain differences in the utilization of carbon and nitrogen sources and fermentation conditions among different strains belonging to the same genus. These differences may be related to the genetic, physiological characteristics, isolation sources, and the evaluation of the antifungal activity of pathogenic targets of the strains themselves [
58]. Additionally, the current study found that the active compounds in the fermentation broth of actinomycete strain TCS21-117 demonstrated remarkable stability against various environment conditions, including thermal, pH level, storage, and UV light exposure time. This stability is a significant advantage for the development and application of biocontrol agents based on this strain.
The use of
Streptomyces strain TCS21-117 as a biocontrol agent offers significant environmental advantages over chemical fungicides, which are associated with soil and water pollution, toxicity to non-target organisms, and risks to human health. In contrast,
Streptomyces-based agents are environmentally sustainable and pose minimal ecological hazards. Studies have demonstrated that
Streptomyces strains can reduce chemical fungicide while maintaining crop yields [
59]. The fermentation broth of TCS21-117 exhibited strong antifungal activity against
B. cinerea, underscoring its potential as an effective alternative to chemical fungicides. Furthermore,
Streptomyces spp. are known to degrade pesticide residues, enhancing soil health and reducing environmental contamination [
60]. The active compounds produced by TCS21-117 also demonstrated high stability under thermal, pH, and UV stress, supporting their suitability for field applications. Therefore, TCS21-117 represents a promising, eco-friendly alternative for sustainable agriculture. Further studies will be conducted on the isolation and characterization of bioactive compounds, and studies on antagonistic mechanisms will be carried out.